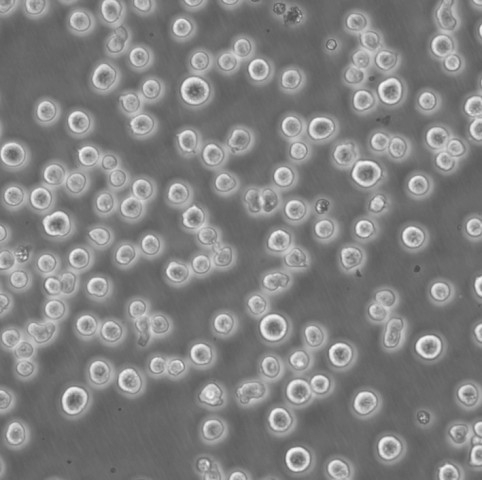
MC38 Cells#结肠癌细胞系源头种子库|培养基|STR图谱

"MC38 Cells#结肠癌细胞系源头种子库|培养基|STR图谱
换液周期:每周2-3次
生长特性:贴壁生长
背景信息:详见相关文献介绍
在实验室细胞培养过程中,细胞聚集是一个常见的问题,它可能会影响细胞的正常生长、实验结果的准确性等诸多方面。为了防止细胞聚集,科研人员通常会采用多种有效的方法。首先,合适的细胞培养容器表面处理至关重要。许多细胞培养瓶和培养皿会经过特殊的表面处理,例如用亲水性的聚合物涂层。减少细胞之间因为吸附在同一位置而聚集的可能性。酶处理也是常用的手段之一。在细胞消化传代过程中,使用适量的胰蛋白酶等酶试剂。胰蛋白酶能够分解细胞间的连接蛋白,使细胞彼此分离。但是,酶的浓度和处理时间需要严格把控。如果酶浓度过高或者处理时间过长,虽然细胞能够很好地分散,但可能会对细胞造成损伤,影响细胞的活性。以常见的哺乳动物细胞为例,一般使用0.25%的胰蛋白酶,在37℃下处理1-3分钟,就可以有效地将细胞分散开,同时又能保证细胞的健康状态。添加合适的试剂也是防止细胞聚集的有效策略。一些抗聚集剂如乙二胺四乙酸(EDTA)被广泛使用。EDTA能够螯合细胞培养液中的钙、镁离子,而这些离子是细胞间连接所依赖的重要成分。当它们被螯合后,细胞间的连接就会变弱,从而减少聚集。在细胞培养过程中,轻柔的操作也不容忽视。无论是在细胞的接种、换液还是转移过程中,避免剧烈摇晃或吹打。通过这些综合的方法,实验室能够更好地防止细胞聚集,为细胞系培养实验的成功提供保障。
SW 837 Cells;背景说明:详见相关文献介绍;传代方法:1:2—1:5传代,每周换液1-2次;生长特性:悬浮生长;形态特性:上皮细胞;相关产品有:NCIH2122细胞、NCM-460细胞、Kasumi-1细胞
NCI-H322T Cells;背景说明:详见相关文献介绍;传代方法:1:2传代;生长特性:贴壁生长;形态特性:详见产品说明书;相关产品有:Rh30细胞、H-660细胞、BC-PAP细胞
BALB/3T3 cl. A31 Cells;背景说明:胚胎;成纤维;自发永生;雄性;BALB/c;传代方法:1:2-1:3传代;每周换液2-3次。;生长特性:贴壁;形态特性:详见产品说明书;相关产品有:RCK-8细胞、HEK 293-F细胞、CTV-1细胞
WILL-2 Cells;背景说明:弥漫大B淋巴瘤;女性;传代方法:1:2-1:3传代;每周换液2-3次。;生长特性:悬浮;形态特性:详见产品说明书;相关产品有:Baby Hamster Kidney from litter No. 21细胞、BMF细胞、NCIH2172细胞
┈订┈购(技术服务)┈热┈线:1┈3┈6┈4┈1┈9┈3┈0┈7┈9┈1【微信同号】┈Q┈Q:3┈1┈8┈0┈8┈0┈7┈3┈2┈4;
产品包装:复苏发货:T25培养瓶(一瓶)或冻存发货:1ml冻存管(两支)
传代比例:1:2-1:4(首次传代建议1:2)
购买的细胞死亡或细胞存活率不佳可能原因?研究人员在细胞培养时出现存活率不佳,原因比较复杂,常见原因可归纳为:培养基使用错误或培养基品质不佳;血清使用错误或血清的品质不佳;解冻过程错误;冷冻细胞解冻后,加以洗涤细胞和离心;悬浑细胞误认为死细胞;培养温度使用错误;细胞置于-80℃太久等。建议严格参照AC的标准操作规程进行细胞复苏、冻存等工作。欲将一般动物细胞离心下来,其离心速率应为多少转速?欲回收动物细胞,其离心速率一般为300×g(约1OOOrpm),5-10分钟,转速过GAO或离心时间过长都将造成细胞死亡。合适的离心转速是根据相对离心力决定。RCF=1.119×105×r×(rpm)2,其中r为离心机转轴中心与离心套管底部内壁的距离;rpm为离心机每分钟的转数;RCF(relaive nrifugal for)为相对离心力,以重力加速度g(980.66cm/s2)的倍数来表示单位。
来源说明:细胞主要来源ATCC、ECACC、DSMZ、RIKEN等细胞库
KU-812 Cells;背景说明:详见相关文献介绍;传代方法:1:2传代。3天内可长满;生长特性:悬浮生长;形态特性:骨髓母细胞;相关产品有:PC14细胞、2008细胞、NKT细胞
KU-812 Cells;背景说明:详见相关文献介绍;传代方法:1:2传代。3天内可长满;生长特性:悬浮生长;形态特性:骨髓母细胞;相关产品有:PC14细胞、2008细胞、NKT细胞
MFE 296 Cells;背景说明:详见相关文献介绍;传代方法:1:2传代;生长特性:贴壁生长;形态特性:详见产品说明书;相关产品有:SK UT 1细胞、RPMI-7666细胞、NCI-SNU-1040细胞
H-4 Cells;背景说明:H4细胞系建系于1973年。它衍生于一个患神经胶质瘤的37岁病人的脑组织。该细胞的致瘤特性己经被屏蔽,细胞接种动物一般不产生肿瘤结节。该细胞具有修复MNNG损伤5型腺病毒的能力。;传代方法:1:3传代,每周换液2-3次。;生长特性:贴壁生长;形态特性:上皮样;相关产品有:MV522细胞、EOC20细胞、RBL 1细胞
tdott Cells;背景说明:详见相关文献介绍;传代方法:10^5 cells/60mm dish;生长特性:贴壁生长;形态特性:上皮细胞样;相关产品有:PANC0813细胞、PC-3M-2B4细胞、U-2932细胞
物种来源:人源、鼠源等其它物种来源
MC38 Cells#结肠癌细胞系源头种子库|培养基|STR图谱
形态特性:上皮细胞样
┈订┈购(技术服务)┈热┈线:1┈3┈6┈4┈1┈9┈3┈0┈7┈9┈1【微信同号】┈Q┈Q:3┈1┈8┈0┈8┈0┈7┈3┈2┈4;
贴壁细胞的传代培养,详细步骤如下:首先倒掉培养基,在这一步骤可以收集一些细胞上清做支原体检测;加入胰蛋白酶,一般T25是加2mL,盖好瓶盖,摇晃T25培养瓶,使胰蛋白酶均匀覆盖在细胞表面,放入培养箱2-3min,期间可在显微镜下观察,看到大部分细胞变圆,即可放入超净台,加入2倍的完全培养基,这里就是加4mL培养基,终止消化;将含有胰蛋白酶,细胞和培养基一起转移到离心管中,1000rpm/3min离心,去掉上清;新鲜的完全培养基重悬,根据细胞的生长特性和后续的实验需求进行传代,比如我养的Hepa1-6就长的比较快,不是着急用的话,我就会按1E6个细胞/T75培养瓶进行传代;但如果后两天要用,就会适当多传一点;还可通过显微镜计数后,直接用于细胞铺板,继续后续的实验。
Abcam HEK293T FTSJ1 KO Cells(提供STR鉴定图谱)
AG10240 Cells(提供STR鉴定图谱)
BayGenomics ES cell line NST020 Cells(提供STR鉴定图谱)
BayGenomics ES cell line XC705 Cells(提供STR鉴定图谱)
BT474 A3 Cells(提供STR鉴定图谱)
CpDW10 Cells(提供STR鉴定图谱)
DA04099 Cells(提供STR鉴定图谱)
Ff-CLs31 Cells(提供STR鉴定图谱)
GM08662 Cells(提供STR鉴定图谱)
MC9 Cells;背景说明:肥大细胞;C57BL/6 x A/J;传代方法:1:2-1:3传代;每周换液2-3次。;生长特性:悬浮;形态特性:详见产品说明书;相关产品有:CCD1112Sk细胞、KYSE-180细胞、0V-1063细胞
OVCAR.5 Cells;背景说明:卵巢癌;腹水转移;女性;传代方法:1:2-1:3传代;每周换液2-3次。;生长特性:贴壁;形态特性:详见产品说明书;相关产品有:NCI-H2052细胞、LCLC103H细胞、NS1-Ag4细胞
SKNEP Cells;背景说明:超微结构有少许微绒毛,连接复合物,形态完整的高尔基体,内质网多为光滑型,脂滴,没有病毒棵粒。;传代方法:1:2传代。3天内可长满。;生长特性:半贴壁生长;形态特性:上皮细胞;相关产品有:U-138MG细胞、U14细胞、BIC1细胞
HeLa-229 Cells;背景说明:宫颈癌;女性;传代方法:1:2-1:3传代;每周换液2-3次。;生长特性:贴壁;形态特性:详见产品说明书;相关产品有:HEK 293T/17细胞、HSC-5 [Human skin squamous cell carcinoma]细胞、SP2/0 Ag-14细胞
NCIH1963 Cells;背景说明:详见相关文献介绍;传代方法:每周换液2次。;生长特性:悬浮生长;形态特性:详见产品说明书;相关产品有:C1498细胞、NR-8383细胞、ES2细胞
ST Cells;背景说明:ST细胞系建系于1960年(Mcclurkin,AW,etal)。ST细胞一般用于病毒增殖和分离,是猪细小病毒的理想宿主,可用于这类病毒的分离及增殖。;传代方法:1:3传代,2-3天传一代;生长特性:贴壁生长;形态特性:上皮细胞样;相关产品有:HGF-1细胞、THPI细胞、RGM-1细胞
UCLA NPA-87-1 Cells;背景说明:详见相关文献介绍;传代方法:1:2-1:3传代;每周换液2-3次。;生长特性:贴壁或悬浮,详见产品说明书部分;形态特性:详见产品说明书;相关产品有:SNU-16细胞、MHCC97-L细胞、HCC78细胞
MC38 Cells#结肠癌细胞系源头种子库|培养基|STR图谱
HBSMC Cells;背景说明:详见相关文献介绍;传代方法:1:2-1:3传代;每周换液2-3次。;生长特性:贴壁或悬浮,详见产品说明书部分;形态特性:详见产品说明书;相关产品有:Hs 832(C).T细胞、SW1222细胞、CWR22R细胞
NCIH810 Cells;背景说明:详见相关文献介绍;传代方法:1:2-1:6传代,每周2-3次。;生长特性:贴壁生长;形态特性:上皮样;相关产品有:NCI-H2126细胞、NFHIOSE-29细胞、LS513细胞
SW-948 Cells;背景说明:详见相关文献介绍;传代方法:1:2—1:5传代,每周换液1-2次;生长特性:贴壁生长;形态特性:上皮细胞样;相关产品有:SW 1573细胞、CL-34细胞、SKG-3a细胞
IPLB-SF 21 Cells;背景说明:详见相关文献介绍;传代方法:1:2-1:3传代;每周换液2-3次。;生长特性:贴壁或悬浮,详见产品说明书部分;形态特性:详见产品说明书;相关产品有:HITT15细胞、RIN Cl-5F细胞、CLL-CII细胞
H-3255 Cells;背景说明:详见相关文献介绍;传代方法:1:2传代;生长特性:贴壁生长 ;形态特性:详见产品说明书;相关产品有:HT 1080细胞、RL95细胞、B16-F10--RED细胞
Hs746-T Cells;背景说明:详见相关文献介绍;传代方法:1:2-1:3传代;每周换液2-3次。;生长特性:贴壁或悬浮,详见产品说明书部分;形态特性:详见产品说明书;相关产品有:DU 4475细胞、NCI-H2126细胞、KY-270细胞
RL-95-2 Cells;背景说明:这些细胞有α角蛋白,定义明确的连接复合体,张力丝和表面微绒毛。;传代方法:1:2传代;生长特性:贴壁生长;形态特性:上皮样;相关产品有:SK-ES-1细胞、Y3-Ag123细胞、SUDHL2细胞
SK-N-BE(1)n Cells;背景说明:详见相关文献介绍;传代方法:1:2-1:3传代;每周换液2-3次。;生长特性:贴壁或悬浮,详见产品说明书部分;形态特性:详见产品说明书;相关产品有:NSC34细胞、H-2023细胞、EAHY-926细胞
┈订┈购(技术服务)┈热┈线:1┈3┈6┈4┈1┈9┈3┈0┈7┈9┈1【微信同号】┈Q┈Q:3┈1┈8┈0┈8┈0┈7┈3┈2┈4;
HEC-251 Cells;背景说明:子宫内膜癌;女性;传代方法:1:2-1:3传代;每周换液2-3次。;生长特性:贴壁;形态特性:详见产品说明书;相关产品有:GM17346细胞、SV40-MES13细胞、MDA-MB361细胞
MHCC97 Cells;背景说明:详见相关文献介绍;传代方法:1:2-1:3传代;每周换液2-3次。;生长特性:贴壁或悬浮,详见产品说明书部分;形态特性:详见产品说明书;相关产品有:SK N SH细胞、BPH1细胞、LN299细胞
HuNS1 Cells;背景说明:详见相关文献介绍;传代方法:2-3天换液1次。;生长特性:悬浮生长 ;形态特性:淋巴母细胞样;相关产品有:HHFK细胞、MPASMC细胞、ACHN细胞
KOPN-8 Cells;背景说明:B淋巴细胞白血病;女性;传代方法:1:2-1:3传代;每周换液2-3次。;生长特性:悬浮;形态特性:详见产品说明书;相关产品有:NCI-H1954细胞、FRO 81-2细胞、SW 1088细胞
HRA-19 Cells;背景说明:详见相关文献介绍;传代方法:1:2-1:3传代;每周换液2-3次。;生长特性:贴壁或悬浮,详见产品说明书部分;形态特性:详见产品说明书;相关产品有:NCI-H441细胞、aTC1-6细胞、HL 60细胞
H-1770 Cells;背景说明:详见相关文献介绍;传代方法:随细胞的生长而换液;生长特性:悬浮生长;形态特性:详见产品说明书;相关产品有:RSC 96细胞、Fetal Human Lens-124细胞、PLC/PRF/5细胞
WM-239 Cells;背景说明:黑色素瘤;女性;传代方法:1:2-1:3传代;每周换液2-3次。;生长特性:贴壁;形态特性:详见产品说明书;相关产品有:C8D1A细胞、Kit 225-K6细胞、2PK3细胞
EU-2 Cells;背景说明:儿童急性髓系白血病;传代方法:1:2-1:3传代;每周换液2-3次。;生长特性:悬浮;形态特性:详见产品说明书;相关产品有:TE-11细胞、Roswell Park Memorial Institute 7951细胞、NCI-H1404细胞
THLE-2 Cells;背景说明:详见相关文献介绍;传代方法:1:3-1:6传代;2-3天换液1次。;生长特性:贴壁生长;形态特性:上皮样;相关产品有:TALL-1 [Human adult T-ALL]细胞、EBC-1细胞、NPC-TW039细胞
GM03190 Cells;背景说明:1967年,该细胞系KleinE和KleinG建系,源于一名16岁患有Burkitt's淋巴瘤的黑人男性,beta-2-微球蛋白阴性,表达EBNA,VCA,sIg。该细胞携带EB病毒,是一个典型的B淋巴母细胞系,可用于白血病发病机制的研究。;传代方法:1:2传代;生长特性:悬浮生长;形态特性:淋巴母细胞样;相关产品有:H-1092细胞、H69细胞、WiDr/S细胞
JIII Cells;背景说明:单核细胞白血病;传代方法:1:2-1:3传代;每周换液2-3次。;生长特性:悬浮;形态特性:详见产品说明书;相关产品有:MDA-MB-468细胞、LS1034细胞、3D4/21细胞
LWnt-3A Cells;背景说明:详见相关文献介绍;传代方法:1:2-1:3传代;每周换液2-3次。;生长特性:贴壁或悬浮,详见产品说明书部分;形态特性:详见产品说明书;相关产品有:A549 ATCC细胞、Epstein-Barr-3细胞、DMS 114细胞
NS-20Y Cells;背景说明:神经母细胞瘤;雄性;A/J;传代方法:1:2-1:3传代;每周换液2-3次。;生长特性:贴壁;形态特性:详见产品说明书;相关产品有:CCRF CEM细胞、VK2细胞、U2932细胞
HAP1 ADCY3 (-) 1 Cells(提供STR鉴定图谱)
HAP1 SGK1 (-) 3 Cells(提供STR鉴定图谱)
HG02256 Cells(提供STR鉴定图谱)
HyCyte INS-1 KO-rHnf4a Cells(提供STR鉴定图谱)
LCL Orang Asli K32 Cells(提供STR鉴定图谱)
N1E-115 GFP-ADNP p.Pro403* Cells(提供STR鉴定图谱)
OVC.ID.20 Cells(提供STR鉴定图谱)
RST1 Cells(提供STR鉴定图谱)
teno-iPSC1 Cells(提供STR鉴定图谱)
Ubigene U-87 MG NFE2L2 KO Cells(提供STR鉴定图谱)
ZEC-127 Cells(提供STR鉴定图谱)
Ba/F3 EGFR-Ex19del/C797S Cells(提供STR鉴定图谱)
QSG-7701 Cells;背景说明:该细胞系来自35岁女性的肝癌癌旁组织。;传代方法:消化3-5分钟,1:2,3天内可长满;生长特性:贴壁生长;形态特性:上皮样;相关产品有:SW 626细胞、Y3-Ag1.2.3细胞、RPTC细胞
Vero C1008 Cells;背景说明:详见相关文献介绍;传代方法:1:2-1:3传代;每周换液2-3次。;生长特性:贴壁或悬浮,详见产品说明书部分;形态特性:详见产品说明书;相关产品有:COLO 206F细胞、SU 86.86细胞、TW01细胞
NCI-H747 Cells;背景说明:详见相关文献介绍;传代方法:1:2—1:4传代,每周换液2次;生长特性:贴壁生长;形态特性:上皮样;相关产品有:C 6细胞、BIC-1细胞、MDAMB134VI细胞
Kasumi 1 Cells;背景说明:详见相关文献介绍;传代方法:1:2传代。3天内可长满。;生长特性:悬浮生长;形态特性:原粒细胞;相关产品有:Nb2-11细胞、PC.3细胞、SK_N_FI细胞
Human Lung Microvascular Endothelial Cell line-5a Cells;背景说明:肺微血管;内皮细胞;SV40转化;传代方法:1:2-1:3传代;每周换液2-3次。;生长特性:贴壁;形态特性:详见产品说明书;相关产品有:HS940细胞、S.B.细胞、Ca761细胞
KY70 Cells;背景说明:详见相关文献介绍;传代方法:1:2-1:3传代;每周换液2-3次。;生长特性:贴壁或悬浮,详见产品说明书部分;形态特性:详见产品说明书;相关产品有:MC3T3-E1 Subclone 4细胞、SNU398细胞、Malme-3M细胞
NTC-200 Cells;背景说明:详见相关文献介绍;传代方法:1:2传代;生长特性:贴壁生长;形态特性:上皮样;相关产品有:Panc-05.04细胞、MDAMB-231细胞、K7M2 wt细胞
SNB-19 Cells;背景说明:详见相关文献介绍;传代方法:1:2传代;生长特性:贴壁生长 ;形态特性:详见产品说明书;相关产品有:LP1细胞、CCD18细胞、SKOV3细胞
SCI1 Cells;背景说明:胚胎;自发永生;传代方法:1:2-1:3传代;每周换液2-3次。;生长特性:贴壁;形态特性:详见产品说明书;相关产品有:HC11 Mammary Epithelium细胞、SK-NSH细胞、PIGI细胞
CL40 Cells;背景说明:详见相关文献介绍;传代方法:1:2-1:3传代;每周换液2-3次。;生长特性:贴壁或悬浮,详见产品说明书部分;形态特性:详见产品说明书;相关产品有:HEK-293H细胞、Immortal Pig Intestinal-2I细胞、B16BL-6细胞
JJN-3 Cells;背景说明:详见相关文献介绍;传代方法:1:2-1:3传代;每周换液2-3次。;生长特性:贴壁或悬浮,详见产品说明书部分;形态特性:详见产品说明书;相关产品有:HOC1细胞、CW2细胞、UMUC14细胞
CMK Cells;背景说明:详见相关文献介绍;传代方法:1:2-1:3传代;每周换液2-3次。;生长特性:贴壁或悬浮,详见产品说明书部分;形态特性:详见产品说明书;相关产品有:LS-411细胞、CV-1细胞、NCI-H128细胞
H841 Cells;背景说明:详见相关文献介绍;传代方法:1:3—1:5传代,;生长特性:混合型生长;形态特性:详见产品说明书;相关产品有:B16 F1细胞、MonoMac1细胞、TE-671细胞
NCIH2085 Cells;背景说明:详见相关文献介绍;传代方法:1:3-1:6传代 ;生长特性:贴壁生长;形态特性:上皮细胞;相关产品有:Hs840T细胞、Mino细胞、IEC6细胞
OCILY10 Cells;背景说明:弥漫大B细胞淋巴瘤;传代方法:1:2-1:3传代;每周换液2-3次。;生长特性:悬浮;形态特性:详见产品说明书;相关产品有:HLF-a细胞、RSMC细胞、C3H10T1/2 clone8细胞
A549ATCC Cells;背景说明:详见相关文献介绍;传代方法:1:2-1:3传代;每周换液2-3次。;生长特性:贴壁或悬浮,详见产品说明书部分;形态特性:详见产品说明书;相关产品有:H-1435细胞、SJCRH30细胞、RGB细胞
Panc 3.27 Cells;背景说明:详见相关文献介绍;传代方法:1:2传代;生长特性:贴壁生长;形态特性:上皮样;相关产品有:J774细胞、P3JHR-1细胞、HS852.T细胞
16-HBE14o Cells;背景说明:详见相关文献介绍;传代方法:1:2传代;生长特性:贴壁生长 ;形态特性:详见产品说明书;相关产品有:SN12-PM6细胞、HEC1-B细胞、P-388D1细胞
KP-N-NS Cells;背景说明:源自脑转移灶的肾上腺神经母细胞瘤。;传代方法:1:2传代;生长特性:贴壁或悬浮,详见产品说明书部分;形态特性:详见产品说明书;相关产品有:CV 1细胞、NTERA-2cl.D1细胞、OVCAR420细胞
MCF12A Cells;背景说明:非致瘤性乳腺上皮细胞;女性;传代方法:1:2-1:3传代;每周换液2-3次。;生长特性:贴壁;形态特性:详见产品说明书;相关产品有:EST50细胞、NCI-SNU-C2B细胞、GC-2细胞
D283-MED Cells;背景说明:详见相关文献介绍;传代方法:每周换液2-3次。;生长特性:悬浮细胞的多细胞聚集体,和一些贴壁 Cells;形态特性:上皮细胞;相关产品有:MBVP细胞、CAL 78细胞、WM115-mel细胞
CV-1.K Cells;背景说明:CV-1细胞株是1964年由JensenFC等建系的,源自成年雄性非洲绿猴肾,被用于Rous肉瘤病毒的转染研究。可作为SV40载体的转染宿主。;传代方法:1:2传代;生长特性:贴壁生长;形态特性:成纤维细胞样;相关产品有:OVMANA细胞、Ku812F细胞、RH8994细胞
NGEC Cells;背景说明:胃黏膜;上皮 Cells;传代方法:1:2-1:3传代;每周换液2-3次。;生长特性:贴壁;形态特性:详见产品说明书;相关产品有:Duke University 145细胞、TCam-2细胞、SF-763细胞
NFS 60 Cells;背景说明:详见相关文献介绍;传代方法:1:3传代;生长特性:贴壁生长;形态特性:上皮细胞样;相关产品有:CHO细胞、NCI-SNU-761细胞、Malme3M细胞
H292 Cells;背景说明:详见相关文献介绍;传代方法:1:3-1:8传代;2-3天换液1次。;生长特性:贴壁生长;形态特性:上皮样;相关产品有:SNU620细胞、BALB/3T3 clone A31细胞、NCI-H157细胞
IOSE-Mar Cells;背景说明:卵巢;上皮细胞;女性;传代方法:1:2-1:3传代;每周换液2-3次。;生长特性:贴壁;形态特性:详见产品说明书;相关产品有:4T1-A细胞、GM02132细胞、SEG1细胞
HET1A Cells;背景说明:食管;上皮细胞;SV40转化;男性;传代方法:1:2-1:3传代;每周换液2-3次。;生长特性:贴壁;形态特性:详见产品说明书;相关产品有:COR-L279细胞、Mv 1 Lu细胞、HAVSMC细胞
Hs 675.T Cells;背景说明:详见相关文献介绍;传代方法:1:2-1:3传代,每周2-3次。;生长特性:贴壁生长;形态特性:成纤维细胞;相关产品有:PanC1细胞、KYSE-270细胞、NHEK细胞
Rat Chondrosarcoma Swarm Cells;背景说明:软骨肉瘤;SD;传代方法:1:2-1:3传代;每周换液2-3次。;生长特性:贴壁;形态特性:详见产品说明书;相关产品有:HL1细胞、HEK-293A细胞、MES 23.5细胞
COLO320 DM Cells;背景说明:该细胞可产生5-羟色胺、去甲、、ACTH和甲状旁腺素。角蛋白、波形蛋白弱阳性。培养条件: RPMI 1640 10%FBS;传代方法:1:2-1:3传代;每周换液2-3次。;生长特性:悬浮+贴壁;形态特性:淋巴细胞;相关产品有:RCC 7860细胞、A431/P细胞、MDA-1386细胞
GM00637F Cells;背景说明:详见相关文献介绍;传代方法:1:2-1:3传代;每周换液2-3次。;生长特性:贴壁或悬浮,详见产品说明书部分;形态特性:详见产品说明书;相关产品有:TMD-8细胞、H766T细胞、X63-Ag8细胞
┈订┈购(技术服务)┈热┈线:1┈3┈6┈4┈1┈9┈3┈0┈7┈9┈1【微信同号】┈Q┈Q:3┈1┈8┈0┈8┈0┈7┈3┈2┈4;
MDA-MB-468 Cells;背景说明:该细胞是1977年由CailleauR等从一位患有转移性乳腺癌的51岁黑人女性的胸腔积液中分离得到的。虽然供体组织的G6PD等位基因杂合,但此细胞株始终表现为G6PDA表型。P53基因273位密码子存在G→A突变,从而导致Arg→His替代。每个细胞上存在1×106个EGF受体。;传代方法:1:2-1:4传代;2-3天换液1次;生长特性:贴壁生长;形态特性:上皮样;相关产品有:V79-4细胞、H82细胞、Ra No. 1细胞
D-341Med Cells;背景说明:详见相关文献介绍;传代方法:每周换液2-3次。;生长特性:悬浮生长;形态特性:髓母细胞样;相关产品有:MT2细胞、hTERT-HPNE细胞、RPMI #8226细胞
MC38 Cells#结肠癌细胞系源头种子库|培养基|STR图谱
OCI-AML-4 Cells;背景说明:急性髓系白血病;女性;传代方法:1:2-1:3传代;每周换液2-3次。;生长特性:悬浮;形态特性:详见产品说明书;相关产品有:SK-N-DZ细胞、RPMI-6666细胞、HEM-L细胞
CA-46 Cells;背景说明:该细胞源自Burkitt's淋巴瘤患者的B淋巴细胞,EBNA、Fc阴性。;传代方法:1:2传代;生长特性:悬浮生长;形态特性:淋巴母细胞样;相关产品有:B-95-8细胞、CCD-1095Sk细胞、PCI-4B细胞
SU.86 Cells;背景说明:详见相关文献介绍;传代方法:1:2传代;;生长特性:贴壁生长;形态特性:详见产品说明书;相关产品有:TCam-2细胞、SW839细胞、CMT 64细胞
H1703 Cells;背景说明:该细胞1987年建系,源自一位54岁患有非小细胞肺癌的白人男性,该患者为吸烟者。;传代方法:1:3—1:6传代,每周换液2—3次;生长特性:贴壁生长;形态特性:上皮细胞样;相关产品有:LTEP-sm 1细胞、LU-65M细胞、SKNBE(2c)细胞
3T6-Swiss albino Cells;背景说明:胚胎;成纤维;自发永生;雄性;Swiss albino;传代方法:1:2-1:3传代;每周换液2-3次。;生长特性:贴壁;形态特性:详见产品说明书;相关产品有:HCC-9724细胞、MCA38细胞、293S细胞
BayGenomics ES cell line RRR221 Cells(提供STR鉴定图谱)
BayGenomics ES cell line YHD191 Cells(提供STR鉴定图谱)
HT22 Cells(提供STR鉴定图谱)
PCRP-HES1-2E8 Cells(提供STR鉴定图谱)
EPI Cells(提供STR鉴定图谱)
HPS2647 Cells(提供STR鉴定图谱)
"